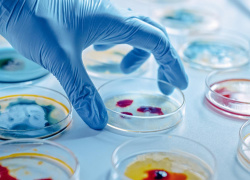

Benvenuti al National, dove Eleganza, Relax e Business si incontrano in un luogo speciale
Se la vostra ricerca è di una vacanza benessere al mare, il nostro albergo a 4 stelle a Rimini direttamente sul mare è la scelta ideale per soddisfare la vostra voglia di relax a due passi dalla spiaggia nella zona più esclusiva di Rimini, Marina Centro. L’atmosfera raffinata che si respira renderà la tua vacanza a Rimini indimenticabile, in un ambiente confortevole e ricercato, moderno ed accogliente che si coniuga sapientemente con servizi di pregio, tra mobili d’epoca e fini porcellane, ampi saloni dove ogni dettaglio è curato al massimo. Nelle nostre camere ampie dotate di comfort di livello internazionale troverete tutto il relax che cercate in una vacanza al mare, dove gusto, tranquillità ed eleganza vi avvolgeranno per il vostro piacere. Insonorizzate e dotate di balconi e grandi terrazze, da ogni camera potrete godere di una meravigliosa vista su mare e lungomare di Rimini, un panorama unico e dal fascino inestinguibile.
All'hotel National troverete tutto quello che in un hotel 4 stelle a Rimini non può mancare: ristorante panoramico di classe Zafferano, piscina privata riscaldata (estiva), zona fitness con sauna e bagno turco, minipiscina idromassaggio Teuco, massaggi e tanti altri trattamenti per una vera vacanza di benessere a Rimini. La nostra SPA "Oasi del Benessere" è centro Wellness e centro Benessere e si trova al piano attico. Il nostro hotel direttamente sul mare ideale per famiglie e con uno staff sempre all'altezza vi sembrerà di vivere un sogno, ma non solo d'estate, infatti da noi potrete godere appieno delle vacanze natalizie e capodanno e dei ponti primaverili. Noi della famiglia Grossi siamo albergatori a Rimini da oltre cent’anni ed abbiamo fatto dell’accoglienza il nostro punto di forza, vi aspettiamo.
L'hotel 4 stelle National è anche perfetto per i vostri soggiorni di lavoro a Rimini, poco distante dal quartiere fieristico e dal Palacongressi di Rimini. Se siete nella città romagnola per un incontro di lavoro non perdete l’occasione di scegliere una location di classe per i vostri appuntamenti, con tutte le facilities offerte dall’hotel per eventi di successo, grazie anche alle nostre sale riunioni che possono variare dagli 8 ai 250 posti.
Siamo noti nel panorama business per la vicinanza del nostro hotel al palacogressi di Rimini per offrire i migliori servizi legati al mondo degli affari. Oltre ai servizi in hotel, il National offre servizi su richiesta di bus navetta verso i principali punti d’interesse della città, compresi il quartiere fieristico di Rimini Fiera ed il nuovo Palacongressi di Rimini.

Sogni il mare per l’estate 2026?Estate 2026: la scelta di una vacanza senza pensieri Anticipa i tuoi sogni d’estate: prenotando entro il 15 marzo 2026 risparmi il 15%.Massima flessibilità: cambia le date...
Beer & Food Attraction Rimini: la fiera della birra artigianale si terrà a Rimini Fiera dal 21 al 23 febbraio 2027 Dal 21 al 23 febbraio 2026, la Fiera di Rimini...

Music Inside Rimini alla fiera di Rimini dal 12 al 14 aprile 2026, scopri la nostra offerta a tutto volume! Non farti scappare la possibilità di partecipare a MIR Tech dal 12...

ENADA PRIMAVERA torna alla Fiera di Rimini per la sua 38° edizione dal 17 al 19 marzo2026 Enada Primavera è la fiera leader per tutti gli operatori del settore gaming nel Sud Europa ed è un’occasione unica per...

Se parteciperai al Meeting 2026, l'Hotel National è la scelta giusta per te! “Nei luoghi deserti costruiremo con mattoni nuovi”: è questo il tema della 47ª edizione del Meeting per l’amicizia...

Ti aspettiamo al National Hotel per partecipare al Congresso SCIVAC dal 29 al 31 Maggio 2026! Il congresso Scivac ritorna al Palacongressi di Rimini dal 29 al 31 Maggio 2026. Organizzerà...

Torna a Rimini Fiera il goloso appuntamento con Sigep 2027: scopri la speciale offerta del National Hotel Fronte Mare! Sigep - The Dolce World Expo, l'appuntamento professionale più importante al mondo...

Ti aspettiamo al National Hotel per partecipare al Congresso SIR dal 25 al 28 Novembre 2026! Il Congresso SIR 2026, organizzato dalla Società Italiana di Reumatologia, si terrà a Rimini dal...

Pescare Show sbarca a Rimini Fiera a Febbraio 2027 Partecipa al Salone Internazionale della pesca sportiva, della nautica da di porto e outdoor, che si terrà dal 5 al 7 Febbraio...

Parteciperai all'edizione 2026 del Congresso ANMCO? Scopri la soluzione ideale vicino al Palacongressi! Dal 7 al 9 Maggio 2026 avrà luogo presso il Palacongressi di Rimini il 56° Congresso dell'Associazione Nazionale Medici Cardiologi...

MACFRUT: l'evento leader a Rimini per il settore ortofrutticolo si terrà dal 21 al 23 aprile 2026 L'evento che si terrà presso il quartiere fieristico di Rimini ha nuove date: dal...
53° edizione del congresso AMCLI, scopri la nostra offerta speciale! Dal 27 al 30 Marzo 2026 tornerà il Congresso Nazionale AMCLI per discutere le tematiche di Microbiologia Clinica presso il Palazzo...

Siamo lieti di accogliervi al National Hotel **** in occasione di FierAvicola, che si svolgerà dal 21 al 23 aprile 2026 presso Rimini Fiera! Anche quest’anno, FierAvicola ha scelto Rimini come sede...

Scopri la nostra offerta speciale per Marketers World 2026 Il Marketers World è l’evento di riferimento in Italia per imprenditori digitali, creators, freelancer e per tutti coloro che desiderano intraprendere una...

Partecipa al XXIII Congresso Nazionale AIDOR 2026 a Rimini! Il 23° Congresso Nazionale AIDOR, punto di riferimento per gli specialisti in ortodonzia, si terrà a Rimini il 17 e 18 Aprile...

Scegli National Hotel Fronte Mare per un meeting di successo a Rimini! Il National Hotel 4 stelle è perfetto per i vostri soggiorni di lavoro a Rimini: la poca distanza dal...

Vivi la magia della Pasqua sulla Riviera Romagnola! Regalati un soggiorno indimenticabile all’Hotel National fronte mare, dove eleganza, comfort e gusto si incontrano per celebrare la Pasqua in grande stile.
Non mancare all'atteso evento internazionale TECNA - How to make it a Settembre 2026 Tecna rappresenta l’evoluzione di Tecnargilla, la manifestazione tra le più importanti a livello mondiale per la fornitura all’industria...

IBE Intermobility and Bus Expo ritorna dal 24 al 26 novembre 2026 al Quartiere Fieristico di Rimini International Bus Expo si terrà a Rimini Fiera dal 24 al 26 novembre 2026...

Rimini Wellness 2026 presso al National Hotel: scopri le nostre offerte per un soggiorno fitness dal 28 maggio al 31 maggio! Dal 28 maggio al 31 maggio 2026 ritorna la piu importante fiera...

Dal 9 al 17 luglio 2026 la Fiera di Rimini ospiterà nuovamente Ginnastica in Festa Un’occasione speciale per tanti piccoli atleti che gareggeranno in un clima di grande allegria! Se sei un...

Cosmoprof di Bologna 2026: la fiera leader mondiale per l'intera industria della cosmetica e della bellezza professionale La Fiera Cosmoprof torna nel 2026 a Bologna Fiera. Il Salone dedicato alla beauty...

A Rimini Fiera torna Expodental, l'evento dell’associazione delle industrie dentarie italiane UNIDI Dal 14 al 16 Maggio 2026 presso la Fiera di Rimini si terrà l'internazionale Meeting Expodental: la fiera di riferimento...

Scopri la nostra offerta per la nuova edizione di Key Energy che si terrà dal 10 al 12 marzo 2027 La nuova Key Energy, che prende il nome di K.EY, si terrà...

Giunto alla 28esima edizione, dal 3 al 6 Novembre 2026 ti aspetta a Rimini Fiera Ecomondo The Green Technology Expo La fiera Ecomondo dal 3 al 6 novembre 2026 è l’evento che unisce...
Scegli National Hotel di Rimini **** per partecipare al TTG Travel Experience 2026 TTG Travel Experience si prepara anche quest'anno per promuovere il turismo mondiale in Italia e commercializzare l'offerta turistica...

Regalati una notte in Suite Lasciatevi tentare da una fantastica e romantica vacanza in hotel a Rimini 4 stelle con centro benessere, con Suite al piano attico. Abbandonate i vostri sensi...

Regalati due giorni di benessere L'ideale per una pausa benessere per te e la persona amata la trovi da noi all'Hotel National, nel cuore della movida e con un'oasi benessere ideale...

Regalati un giorno indimenticabile di puro benessere Avete voglia di una fuga romantica in compagnia della persona amata? L'Oasi del Benessere del National Hotel vi aspetta per un momento rigenerante in...

Regalati un giorno di relax Un pacchetto hotel + benessere economico e poco impegnativo, per chi si vuol dedicare un piccolo "break" di vero relax.L'Hotel National 4 stelle di Rimini propone per...
El hotel cuenta con excelentes instalaciones, muy ordenado y Limpio.La comida del restaurant exquisita
Pero sobre todo la mabilidad, y respeto por parte de las personas que lo atienden.GraciasUna chica que es la primera vez que la veo de ojos claros! Muy divinay como yo lo llamaba" Chocolat man":
hermosa Gente, hace...
![]()
“Altro che 4 stelle! Ottimo!”
![]()
Tutto perfetto, super pulito ed accogliente! Per non parlare della colazione, squisita e super abbondante. Non posso esprimermi a riguardo il pranzo e la cena perché ho usufruito solamente del servizio bed & breakfast.Meriterebbe una...
![]()
“Perfect spot, right on the beach, friendly staff”
![]()
National hotel was very nice and is deserving of its 4 star ranking. There is one women at the front desk who was so polite and genuinely cared about how I was...
![]()
“Bravi”
![]()
La cura e l'attenzione del personale sono stati notevoli. Tutti, dal parcheggiatore dal Senegal al personale della reception. Il vostro servizio fa una differenza incredibile. La colazione a buffet era uno dei migliori che abbia mai incontrato in un...
![]()
Siamo stati al National per una settimana e il nostro giudizio e'piu' che positivo! Le ragazze alla reception sono gentilissime e Musty e'sempre sorridente e cortese! L'hotel e'molto elegante con una splendida hall e una sala ristorante luminosa e con vista mare. La nostra camera era al...
![]()
Hotel stupendo sul mare un vero 4 stelle s, non manca proprio niente. Cura, gentilezza dello staff, camere silenziose e ben arredate, centro benessere al 6 piano per qualsiasi coccola, il ristorante ottimo da provare tutti i piatti sia di terra che di mare. Insomma bello bello...
![]()
Hotel di gran classe, personale competente e molto cortese. le camere sono spaziose, pulite e con ottime rifiniture interne. Ubicato in un ottima posizione e con un tariffario piu' che onesto per la tipologia della struttura, fa di questo hotel tra i miei preferiti. Consigliatissimo.
recensito il...
![]()
Ho trascorso con mio marito 3 giorni in questo hotel a Rimini , in occasione della Pasqua di quest'anno. Ci siamo trovati molto bene, nonostante il cattivo tempo: personale competente e gentilissimo, cucina eccellente...(dai risotti superlativi ai piatti di pesce ), camera ampia con letto immenso e...
![]()
“Relax”5 su 5 stelleHotel di qualità ,raffinato e ottimo sia per le camere che per ristorante Posizione perfetta sul mare convenzionata ad una spiaggia con privacy e molto organizzata con teli mare e lettini Personale qualificato e gentileI titolari sempre attenti e presenti con disponibilità e savoir...